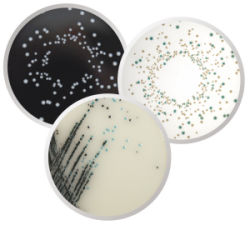

High quality media is needed in various convenient formats, to support a laboratory's microbiology workflows. Neogen believes that culture media is the strong foundation needed to provide reliable testing and results.
Our convenience media products include ready-to-use pre-poured agar plates, bagged and tubed media, as well as our µPREP® ready-to-reconstitute media bags.
These formats allow you to save vital preparation and QC time within your laboratory, allowing you to spend more time elsewhere. They offer flexibility and responsiveness when it comes to spikes in sample volumes, remove congestion from your media kitchen and can help improve your laboratory’s efficiency.
Our wide range reinforces the security of supply, providing you with alternative testing formats to ensure have the product you need, when you need it, in a format that suits you.